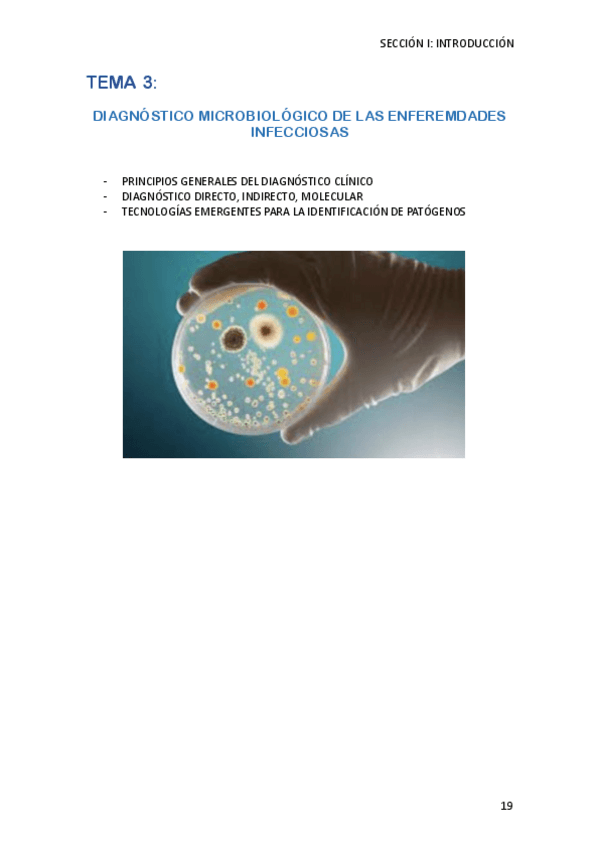

Microbiología Médica
Esquema bacterias con características principales, detección y tratamiento.
Esquema bacterias con características principales, detección y tratamiento.
Esquema bacterias con características principales, detección y tratamiento.
apuntes
-
micro médica
He publicado nuevos apuntes de 3º Microbiología Médica: micro médica
apuntes
-
Apuntes Micromédica
He publicado nuevos apuntes de 3º Microbiología Médica: Apuntes Micromédica
apuntes
-
Apuntes TODO Teoría Microbiología Médica
Resumidos y buenos
apuntes
-
Apuntes
Gracias a los dibujos tuve Matrícula de Honor
apuntes
-
TABLAS RESUMEN BACTERIAS Y VIRUS
He publicado nuevos apuntes de 3º Microbiología Médica: TABLAS RESUMEN BACTERIAS Y VIRUS
apuntes
-
APUNTES microbiología médica
He publicado nuevos apuntes de 3º Microbiología Médica: APUNTES microbiología médica
He publicado nuevos test de 3º Microbiología Médica: Examen-preguntas-bacterias.pdf
apuntes
-
Apuntes completos
He publicado nuevos apuntes de 3º Microbiología Médica: Apuntes completos
He publicado nuevos apuntes de 3º Microbiología Médica: TEMA-7-MICRO-MEDICA.pdf
apuntes
-
PREGUNTAS VIRUS DNA
Preguntas virus DNA
examenes
-
Examen virus
He publicado nuevos examenes de 3º Microbiología Médica: Examen virus
apuntes
-
Microbiología Médica
He publicado nuevos apuntes de 3º Microbiología Médica: Microbiología Médica
ejercicios
-
BOOM
Preguntas BOOM
apuntes
-
Apuntes Micro
He publicado nuevos apuntes de 3º Microbiología Médica: Apuntes Micro
examenes
-
Preguntas parásitos
Preguntas de parásitos para el examen
He publicado nuevos apuntes de 3º Microbiología Médica: Microbiologia-tema-3.pdf
apuntes
-
Virus 2º parcial
He publicado nuevos apuntes de 3º Microbiología Médica: Virus 2º parcial
apuntes
-
APUNTES MICROBIOLOGÍA CLÍNICA 23/24
He publicado nuevos apuntes de 3º Microbiología Médica: APUNTES MICROBIOLOGÍA CLÍNICA 23/24
He publicado nuevos apuntes de 3º Microbiología Médica: PREGUNTAS-TEST-MICROBIOLOGIA-MEDICA.pdf
apuntes
-
Microbiología (2º Parcial)
He publicado nuevos apuntes de 3º Microbiología Médica: Microbiología (2º Parcial)
apuntes
-
Microbiología (1er Parcial)
He publicado nuevos apuntes de 3º Microbiología Médica: Microbiología (1er Parcial)
He publicado nuevos examenes de 3º Microbiología Médica: Preguntas-Virus-Examen-Microbiologia-Medica.pdf
He publicado nuevos apuntes de 3º Microbiología Médica: Tabla-Resumen-tema-7.pdf
apuntes
-
Micro Médica 22-23
He publicado nuevos apuntes de 3º Microbiología Médica: Micro Médica 22-23
apuntes
-
Microbiología COMPLETO 2022-2023
He publicado nuevos apuntes de 3º Microbiología Médica: Microbiología COMPLETO 2022-2023
apuntes
-
Microbiología Médica COMPLETO 2022-2023
He publicado nuevos apuntes de 3º Microbiología Médica: Microbiología Médica COMPLETO 2022-2023
apuntes
-
MicroM 22-23
He publicado nuevos apuntes de 3º Microbiología Médica: MicroM 22-23
apuntes
-
APUNTES TODO MICROMÉDICA
He publicado nuevos apuntes de 3º Microbiología Médica: APUNTES TODO MICROMÉDICA